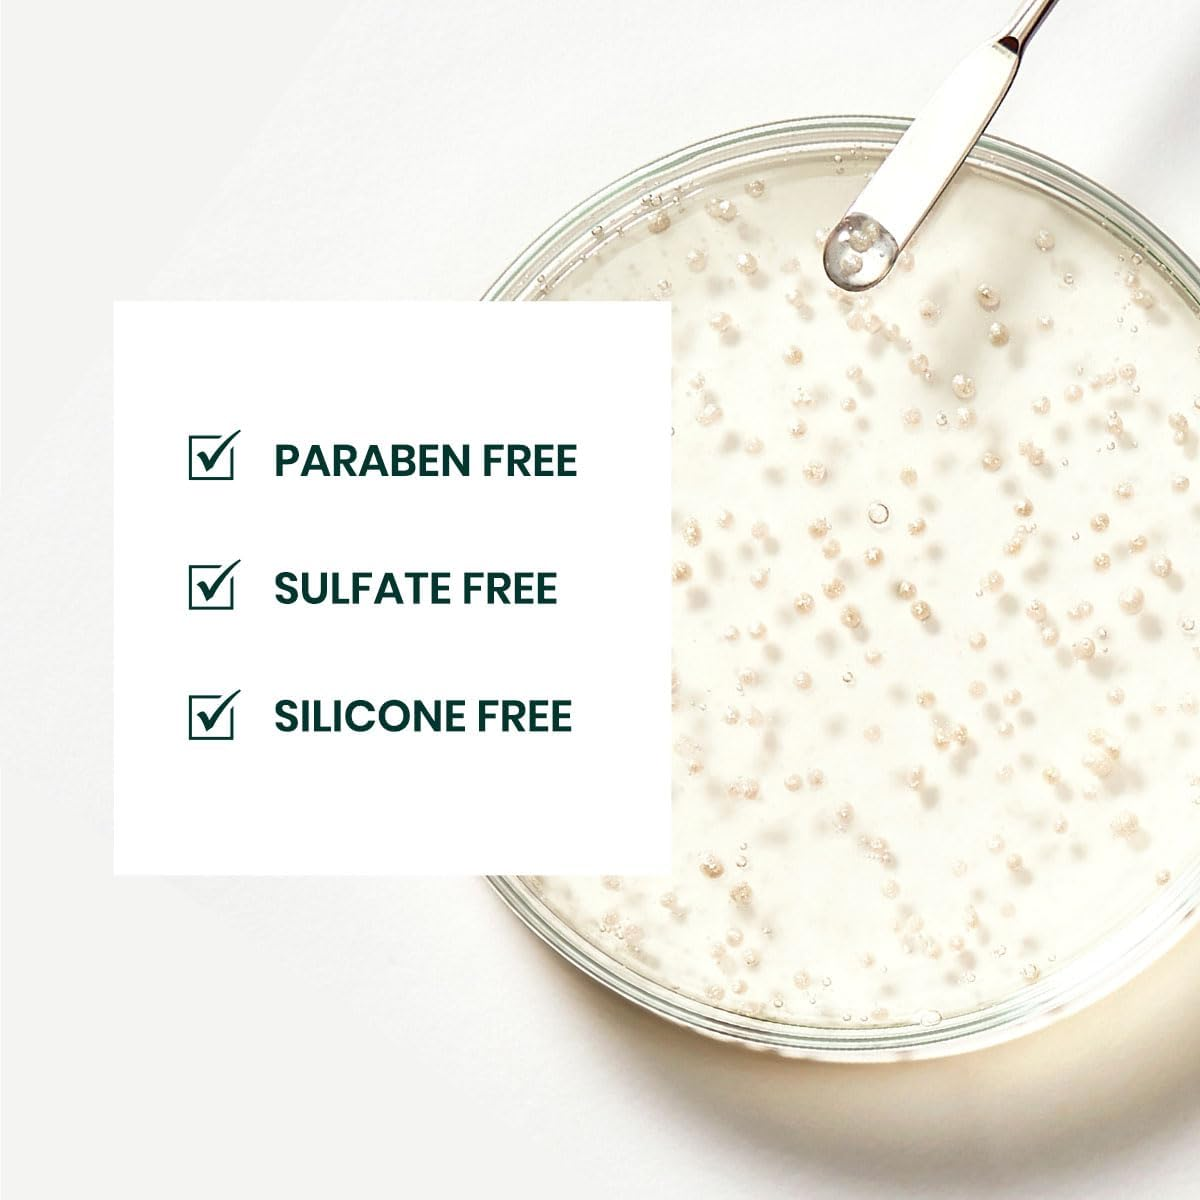
Triphasic by Rene Furterer Anti-Hair Loss Ritual Stimulating Shampoo 50Ml image number 4

Free Shipping – Store Wide
Triphasic by Rene Furterer Anti-Hair Loss Ritual Stimulating Shampoo 50Ml


Triphasic by Rene Furterer Anti-Hair Loss Ritual Stimulating Shampoo 50Ml
Brand: Rene Furterer
A$26.45
- Item Package Length: 3.0cm
- Item Package Width: 4.7cm
- Item Package Height: 10.8cm
- Hair type: Thin
Triphasic AntiHair Loss Ritual Stimulating Shampoo – vital energy, ideal for travel, with practical presentation and vital energy.
- Item Weight: 50 g
- Item Model Number: 3282770109320
- Product dimensions: 3.05 x 5.08 x 10.8 cm; 50 Grams
A$26.45
Shipping to Australia
Delivery time varies by location
Return & Refund Policy
Check our return & refund policy
Security & Privacy
Safe payments: We do not share your personal
details
Availability:
-
In Stock
Sign
in
or create an eMega account
Shop smarter — get exclusive deals & order
tracking